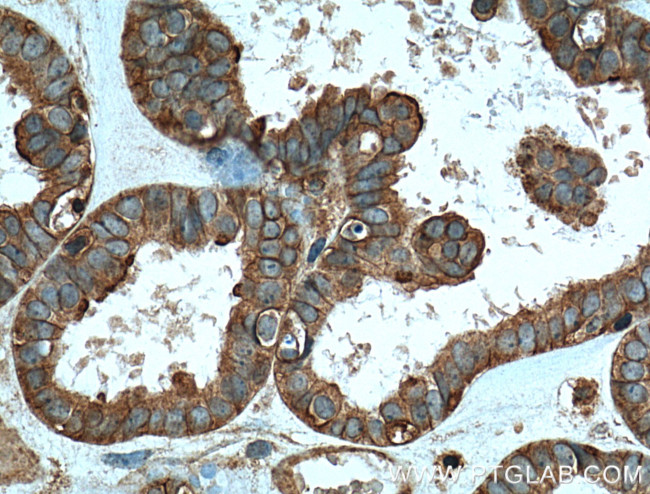
TRIP6 Antibody in Immunohistochemistry (Paraffin) (IHC (P))
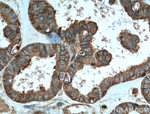
TRIP6 Antibody in Immunohistochemistry (Paraffin) (IHC (P))

Search
Proteintech
TRIP6 Monoclonal Antibody (5D8C7)
{{$productOrderCtrl.translations['antibody.pdp.commerceCard.promotion.promotions']}}
{{$productOrderCtrl.translations['antibody.pdp.commerceCard.promotion.viewpromo']}}
{{$productOrderCtrl.translations['antibody.pdp.commerceCard.promotion.promocode']}}: {{promo.promoCode}} {{promo.promoTitle}} {{promo.promoDescription}}. {{$productOrderCtrl.translations['antibody.pdp.commerceCard.promotion.learnmore']}}
产品信息
60205-1-IG
种属反应
宿主/亚型
分类
类型
克隆号
抗原
偶联物
形式
浓度
规格
纯化类型
保存液
内含物
保存条件
运输条件
产品详细信息
Immunogen sequence: PPPAYRTGS LKPNPASPLP ASPYGGPTPA SYTTASTPAG PAFPVQVKVA QPVRGCGPPR RGASQASGPL PGPHFPLPGR GEVWGPGYRS QREPGPGAKE EAAGVSGPAG RGRGGEHGPQ VPLSQPPEDE LDRLTKKLVH DMNHPPSGEY FGQCGGCGED VVGDGAGVVA FDRVFHVGCF VCSTCRAQLR GQHFYAVERR AYCEGCYVAT LEKCATCSQP ILDRILRAMG KAYHPGCFTC VVCHRGLDGI PFTVDATSQI HCIEDFHRKF APRCSVCGGA IMPEPGQEET VRIVALDRSF HIGCYKCEEC GLLLSSEGEC QGCYPLDGHI LCKACSAWRI QELSATVTTD C (127-476 aa encoded by BC004249)
靶标信息
This gene is a member of the zyxin family and encodes a protein with three LIM zinc-binding domains. This protein localizes to focal adhesion sites and along actin stress fibers. Recruitment of this protein to the plasma membrane occurs in a lysophosphatidic acid (LPA)-dependent manner and it regulates LPA-induced cell migration. Alternatively spliced variants which encode different protein isoforms have been described; however, not all variants have been fully characterized.
仅用于科研。不用于诊断过程。未经明确授权不得转售。
生物信息学
蛋白别名: MGC10556; MGC10558; MGC29959; MGC3837; MGC4423; OIP-1; OPA-interacting protein 1; similar to ZRP-1 and TRIP6; tcag7.1300; thyroid hormone receptor interacting protein 6; Thyroid receptor-interacting protein 6; TR-interacting protein 6; TRIP-6; unnamed protein product; ZRP-1; zyxin related protein 1; Zyxin-related protein 1
基因别名: OIP-1; OIP1; TRIP-6; TRIP6; TRIP6i2; ZRP-1; Zrp1
UniProt ID: (Human) Q15654, (Mouse) Q9Z1Y4
Entrez Gene ID: (Human) 7205, (Mouse) 22051